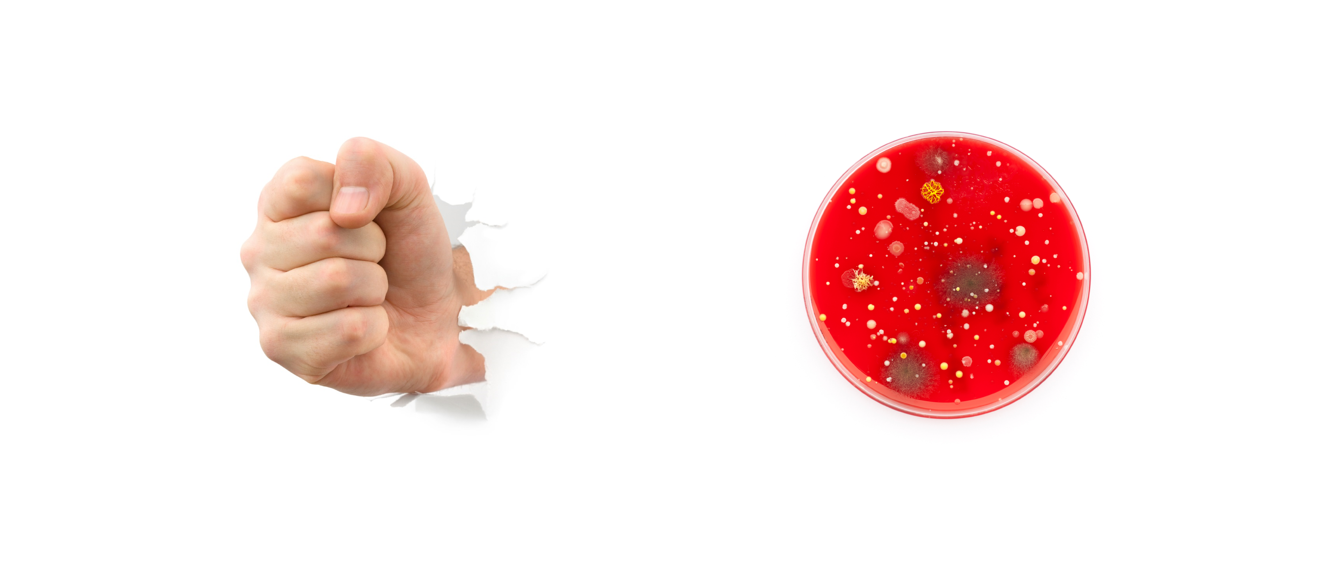

Variedades
O que faz sentido para 2016?
Post escrito por Fernanda Bolzan e Priscila Alvim. Como parte de uma ação para ajudar as pessoas a buscarem mais sentido para suas vidas em 2016, lançamos a campanha “#em2016fazsentido”. Para participar, basta postar no Instagram, Facebook ou Twitter a sua mensagem (foto, vídeo ou texto) sobre o que faz sentido para você. Para inspirar, […]